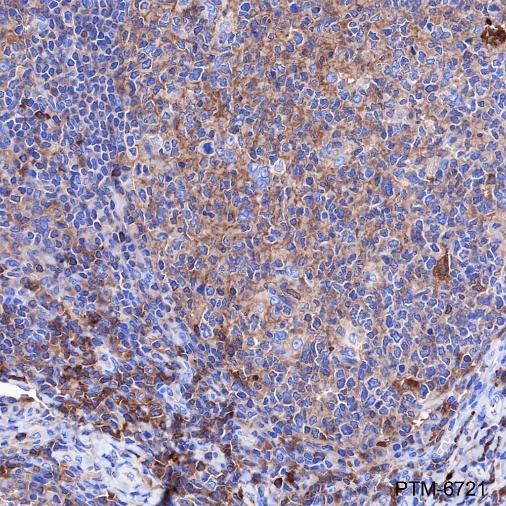

Background
Alpha-1-Antitrypsin (AAT) is a serine protease inhibitor whose targets include elastase, plasmin, thrombin, trypsin, chymotrypsin, and plasminogen activator. AAT is a glycoprotein synthesized primarily by hepatocytes, with smaller amounts synthesized by intestinal epithelial cells, neutrophils, pulmonary alveolar cells and macrophages. AAT is the most abundant, endogenous serine protease inhibitor in blood circulation and it has been implicated in regulating vital fluid phase biological events such as blood coagulation, fibrinolysis, complement activation, apoptosis, reproduction, tumor progression and inflammatory response. The primary function of AAT is thought to be the inactivation of neutrophil elastase and other endogenous serine proteases. Defects in SERPINA1 can cause emphysema or liver disease.
Cellular location
Endoplasmic reticulum